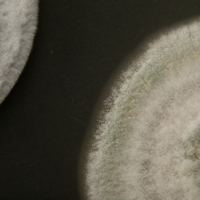

Application
Land application
Metarril should be applied in liquid form, using boom or knapsack sprayers, with the jet spray directed towards the base of the plant. It can be adapted with fan-type nozzle. The volume of mixture should be 250 L/hectares. During application, the mixture must be constantly shaken to ensure it is properly homogenized. The recommendation is 500-700 grams/hectares.
Air application
Metarril should be applied using agricultural aircraft equipped with a boom spray. The ideal flight altitude is 3-4 metres over the crop. The volume of mixture can vary between 40-60 litres/hectares, depending on the equipment used. During application, shake the mixture as necessary to ensure it is properly homogenized. The recommendation is 500-700 grams/hectares.